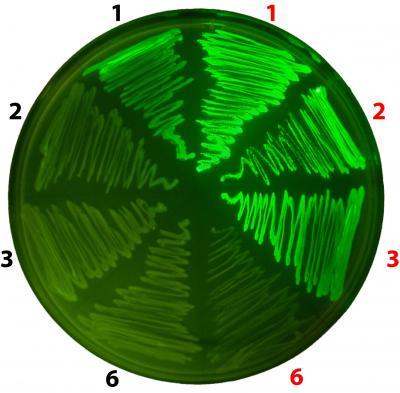

据美国物理学家组织网9月21日报道,美国科学家通过将非天然的氨基酸(除20种用作生物基础元件的天然氨基酸之外的人造氨基酸)整合入蛋白质的多处,成功制造出了新的人造细菌菌株,其可广泛应用于药物研发、药物合成、生物燃料等领域。研究发表在9月18日出版的《自然·化学生物学》杂志上。
该研究的领导者、加州萨克生物研究所化学生物学和蛋白质组学实验室的助理教授王磊(音译)表示:“最新研究向我们展示了新的可能性,包括研制出能在血管中持续更长时间的药物,或采用一种更环保的方式制造化学物质等。”
添加非天然氨基酸让蛋白质功能更强
2001年,王磊和同事首次制造出了蛋白质中整合了非天然氨基酸的细菌;2007年,他们首次在哺乳动物细胞上运用了这项技术。首先,他们制造出了一个“扩展的遗传代码”,并用其覆盖哺乳动物细胞的遗传代码,并指导细胞在蛋白质的构建过程中使用人造氨基酸,从而将人造氨基酸整合进蛋白质中。
王磊解释道,添加非天然氨基酸会改变蛋白质的化学性质,在药物研制以及化学品制造中,新蛋白质会让得到的产品拥有更加丰富而多样的功能。
例如,王磊和同事将受到某些颜色的光照时在显微镜下会发光的非天然氨基酸插入蛋白质中,便可以实时观测到细胞内蛋白质的合成情况,因为蛋白质是大部分细胞执行其功能的基础,这样就有助于科学家们描述与疾病或衰老有关的生物学机制。
现在,已有人使用经过基因修改的细菌来制药,例如用其来合成胰岛素以取代动物胰腺,供糖尿病患者调节其血糖浓度。
将多个非天然氨基酸嵌入蛋白质中
虽然利用DNA(脱氧核糖核酸)重组技术将非天然氨基酸整合入蛋白质中可得到功能更加强大的蛋白质,但在扩展该技术应用范围的前进道路上存在着一个“拦路虎”——一次只能将一个非天然氨基酸整合入蛋白质中。
为了将一个整合过的非天然氨基酸的指令嵌入细菌的遗传代码中,王磊和同事利用了终止密码子——蛋白质遗传蓝图中特殊的代码序列。在蛋白质的制造过程中,终止密码子会告诉细胞机器停止朝形成蛋白质结构骨架的序列增加氨基酸。
2001年,王磊和同事修改了大肠杆菌的遗传序列,选择性地将一个终止密码子嵌入其遗传序列中,同时,他们将转基因分子引入细菌体内,转基因分子将一个非天然氨基酸嵌入终止密码子内,这使细菌能产生有非天然氨基酸集成于其骨架内的蛋白质。
问题在于,名为释放因子1(RF1)的蛋白质会阻止包含非天然氨基酸的蛋白质产生。尽管科学家们能为非天然氨基酸将终止密码子插在遗传序列的多个地方,然而,释放因子会在第一个终止密码子那儿让蛋白质死亡,以预防包含多个非天然氨基酸的长蛋白质产生。
“为了真正地利用该技术,科学家需要能对多处含有非天然氨基酸的蛋白质进行遗传修改,高效地制造出这些蛋白质。”王磊说,“这一点极富潜力,但此前还没有变成现实。”
在最新研究中,萨克生物研究所的科学家和加州大学的同行解决了这个问题。既然RF1会抑制包含多个非天然氨基酸的长蛋白质的产生,所以,科学家们剔除了产生RF1的基因。但RF1基因被移除后,大肠杆菌就会死亡,因此科学家们制造出了RF1的“替身”释放因子2(RF2),RF2能让剔除RF1后的细菌“起死回生”。结果,科学家们得到了一个能有效地将非天然氨基酸整合在多处蛋白质的细菌。
人造细菌具有巨大应用潜力
这些合成出来的细菌在药物研发领域拥有巨大的潜力,据此研制出的药物拥有的生物学功能将远超只包含天然氨基酸的蛋白质。这些分子或许也能作为基础元件,制造从工业溶剂到生物燃料在内的任何产品,帮助解决与石油生产和运输有关的经济和环境问题。
“这是我们首次制造出一个可用的、拥有多处包含非天然氨基酸的蛋白质的细菌菌株。”王磊说,“尽管这项技术还有改进空间,但这使科学家们在生物工程学领域使用非天然氨基酸几乎就快成为现实了。”
生物探索推荐英文论文摘要:
RF1 knockout allows ribosomal incorporation of unnatural amino acids at multiple sites
Stop codons have been exploited for genetic incorporation of unnatural amino acids (Uaas) in live cells, but their low incorporation efficiency, which is possibly due to competition from release factors, limits the power and scope of this technology. Here we show that the reportedly essential release factor 1 (RF1) can be knocked out from Escherichia coli by 'fixing' release factor 2 (RF2). The resultant strain JX33 is stable and independent, and it allows UAG to be reassigned from a stop signal to an amino acid when a UAG-decoding tRNA-synthetase pair is introduced. Uaas were efficiently incorporated at multiple UAG sites in the same gene without translational termination in JX33. We also found that amino acid incorporation at endogenous UAG codons is dependent on RF1 and mRNA context, which explains why E. coli tolerates apparent global suppression of UAG. JX33 affords a unique autonomous host for synthesizing and evolving new protein functions by enabling Uaa incorporation at multiple sites.
